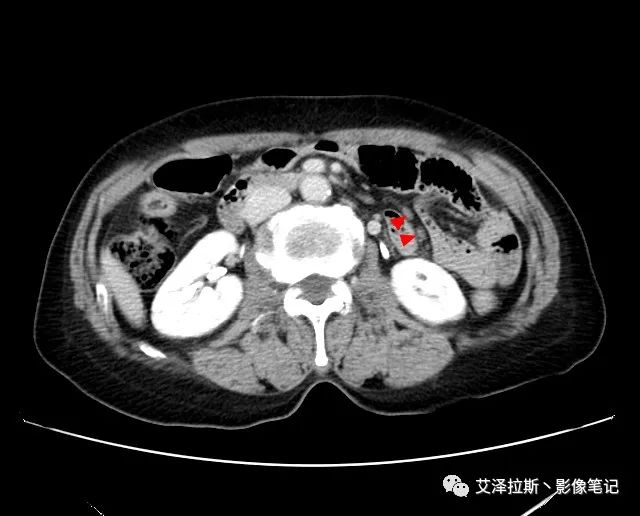

胃癌CT診斷及TNM分期,你想知道的都在這里了
胃癌的螺旋CT分期是胃癌術前分期診斷的主要技術,于手術前對胃癌病變的侵犯范圍、大小及程度進行較準確的估計,避免盲目手術,提高手術切除率,對胃癌治療方案的制訂有著十分重要的指導意義。
病變部位:30% 位于胃竇,30% 位于胃體,30% 位于胃底、賁門,10% 為彌漫浸潤性。
AJCC胃癌TNM分期(第8版)
T——原發腫瘤 Tx:原發腫瘤無法評價; T0:無原發腫瘤的證據; Tis:高度異型增生,局限于上皮內,未侵犯固有層; T1:腫瘤侵及黏膜固有層或黏膜下層 T1a 腫瘤侵及黏膜固有層;T1b 腫瘤侵及黏膜下層; T2:腫瘤侵及固有肌層; T3:腫瘤侵及漿膜下層; T4:T4a 腫瘤侵透漿膜;T4b 腫瘤侵及鄰近器官。
N——區域淋巴結 Nx:區域淋巴結不能評價; N0:無區域淋巴結轉移; N1:1~2個淋巴結轉移; N2:3~6個淋巴結轉移; N3:N3a 7~15個淋巴結轉移;N3b ≥16個淋巴結轉移。
M——遠處轉移 M0:無遠處轉移; M1:有遠處轉移。



T1:低密度的粘膜層保持完整。

T2:胃壁增厚,低密度帶中斷,外輪廓光滑,周圍脂肪層清晰條索影少于1/3。


接下來,小編帶大家通過一典型病例來鞏固一下胃癌TNM分期。
【基本情況】 患者,女性,66歲,貧血。
圖1 平掃+增強各期

圖2 腫瘤



以下為累及的區域淋巴結,共計15個區域:

【影像所見】 胃竇部狹窄,胃壁環形增厚,小彎側見一巨大潰瘍,周圍伴“環堤征”,漿膜面不完整,胃周脂肪見網格狀條索影,病灶與肝臟左葉、胰腺鉤突脂肪間隙消失,增強掃描病灶明顯強化。引流區內約15個區域淋巴結受累。
【診斷意見】 胃竇部胃癌(T4N3期) 該病例腫塊突破漿膜層,與肝臟左葉、胰腺鉤突分界不清,脂肪界面消失,定為T4期; 受累及的淋巴結為15個區域,定為N3; 有無遠處轉移尚不明確,所以M期暫時無法確定。

- 上一篇

胃癌篩查關鍵標志物——胃泌素17
胃癌 胃內壁的黏膜組織內長著厚厚的一層細胞,叫胃黏膜,這些細胞分泌胃液胃酸來幫助我們消化食物。在正常情況下,這些細胞按照人體的需要生長,保持著一定的數量,不多也不少。但是在一些不良的因素的刺激下,個別細胞變成癌細胞,分裂增殖失控長成惡性腫瘤,就是胃癌。中國胃癌現狀1、胃病在我國屬于高發病,民間有“十人九胃”之說,但是胃部疾病容易忽略,
- 下一篇

BMC Cancer:幽門螺桿菌能影響晚期胃癌免疫治療結局?PFS和OS均可相差3倍!
胃癌是全球第五大常見癌癥,也是僅次于肺癌和結直腸癌的第三大癌癥相關死亡原因。盡管診斷為局限性疾病的胃癌患者生存趨勢有所改善,但晚期胃癌(AGC)的預后仍然較差。流行病學數據顯示,被診斷為遠處疾病的胃癌患者的5年生存率仍低于5%。在過去十年中,免疫檢查點抑制劑(ICI)已成為一系列惡性腫瘤的新治療策略。然而,尋找實用的預后標志物以篩選最合適的人群仍在探索。 越
